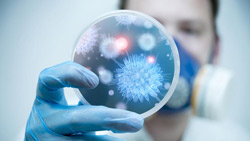

Cercetătorii chinezi au creat în laborator virusuri care pot genera o pandemie ucigaşă de proporţii
Este vorba despre unele experimente ştiinţifice nesăbuite asupra combinării tulpinilor gripei aviare cu cele ale gripei porcine, care ar putea duce în viitor la moartea a zeci de milioane de fiinţe umane
de Aurel Rusu
În mediul natural, unele tulpini de virusuri gripale sunt letale, pe când altele se transmit foarte repede între oameni. Oficialii însărcinaţi cu segmentul pentru sănătate se tem cel mai mult de un hibrid al gripei care să combine acțiunea letală cu transmisibilitatea rapidă, ceea ce ar conduce în scurt timp la o pandemie ucigaşă globală.
În primăvara acestui an, o echipă de cercetători chinezi a publicat în revista Science datele unui experiment controversat, prin care au combinat virusul gripei aviare H5N1, care este letal dar nu se transmite uşor între oameni, cu virusul gripei porcine H1N1, care este extrem de contagios în cazul fiinţelor umane şi care în anul 2009 a fost responsabil de infectarea a zeci de milioane de oameni în SUA (conform datelor CDC, Center for Disease, Control and Prevention).
Invocând găsirea unor noi vaccinuri împotriva gripei, cercetătorii chinezi au creat noi variante foarte periculoase ale gripei ucigaşe H5N1
 Experimentele derulate în laboratorul pentru cercetarea gripei aviare din cadrul Institutului de cercetare veterinară Harbin al Academiei Chineze de Ştiinţe au investigat, potrivit declarațiilor virusologilor chinezi, ceea ce se petrece atunci când animalele sunt infestate cu două tipuri de virusuri. Studiul a fost efectuat în condiţii ridicate de securitate pentru a preveni răspândirea accidentală a virusurilor. Cu toate acestea, din cei 127 de hibrizi obținuți, cinci s-au transmis pe calea aerului, în laborator, porcuşorilor de Guineea.
Experimentele derulate în laboratorul pentru cercetarea gripei aviare din cadrul Institutului de cercetare veterinară Harbin al Academiei Chineze de Ştiinţe au investigat, potrivit declarațiilor virusologilor chinezi, ceea ce se petrece atunci când animalele sunt infestate cu două tipuri de virusuri. Studiul a fost efectuat în condiţii ridicate de securitate pentru a preveni răspândirea accidentală a virusurilor. Cu toate acestea, din cei 127 de hibrizi obținuți, cinci s-au transmis pe calea aerului, în laborator, porcuşorilor de Guineea.
„Studiile au arătat că H5N1 are potenţialitatea de a obţine transmiterea la mamifere prin îmbinarea cu virusul gripei porcine”, a declarat cercetătoarea Hualan Chen, cea care a condus experimentele, într-un mail adresat publicaţiei britanice The Independent.
„Rezultatul cercetărilor ne arată că trebuie să acordăm importanţa cuvenită monitorizării răspândirii unui astfel de virus cu transmitere între mamifere pentru a putea preveni astfel o pandemie ucigaşă provocată de către H5N1. Este dificil să spunem cât de uşor se poate petrece aceasta dar, din moment ce H5N1 şi H1N1 din 2009 există din plin în natură, există posibilitatea ca acestea să se combine.”, a afirmat cercetătoarea Hualan Chen.
Unii oameni de ştiinţă şi-au arătat îngrijorarea cu privire la experimentul chinez
Numeroşi oameni de ştiinţă consideră că riscurile majore pe care le prezintă un astfel de experiment nu sunt compensate de beneficiile rezultate în urma lui. De asemenea, ei atrag atenţia că în ciuda nivelului ridicat de securitate dintr-un laborator, nu se poate garanta anularea oricărei posibilități de apariţie a accidentelor.
Numeroşi oameni de ştiinţă consideră că riscurile majore pe care le prezintă un astfel de experiment nu sunt compensate de beneficiile rezultate în urma lui. De asemenea, ei atrag atenţia că în ciuda nivelului ridicat de securitate dintr-un laborator, nu se poate garanta anularea oricărei posibilități de apariţie a accidentelor.
Oamenii de ştiinţă din Marea Britanie i-au criticat dur pe cercetătorii chinezi, relatează publicaţia engleză The Independent. „Ei susţin că au realizat aceste experimente pentru a ajuta la găsirea unor vaccinuri. Adevăratul motiv este acela că sunt mânaţi de ambiţii oarbe fără niciun fel de bun simţ. Nivelul de securitate al laboratoarelor de genul acesta nu este foarte sigur. Cercetătorii chinezi care au făcut experimentele riscă să creeze virusuri extrem de periculoase cu trasnmitere de la om la om. Este uluitor de iresponsabil din partea lor”, a afirmat Lordul Robert May, fost director al Societăţii Regale din Marea Britanie şi cercetător de marcă al acestei ţări.
La rândul său, profesorul Simon Wain-Hobson, eminent virusolog al Institutului Pasteur din Paris, a apreciat experimentele chineze ca „o capodoperă a virusologiei”, dar a avertizat că această cercetare ar trebui lăsată neterminată. „Baza virologică a acestor cercetări nu este puternică. Nu ajută la dezvoltarea unor vaccinuri, iar beneficiile sale cu privire la monitorizarea unor noi virusuri gripale este supraestimată. Nu cred că îşi dau seama de ceea ce fac. Este îngrijorător”, a mai spus profesorul Wain-Hobson.
 Însă experimentul chinez nu este singular, din păcate. În martie 2012, echipa condusă de cercetătorul Ron Fouchier, din cadrul Centrului Medical Erasmus din Olanda, publica rezultatele unui studiu similar. Din cauza riscurilor evidente asupra biosecurităţii pe care le-a prezentat studiul, comunitatea oamenilor de ştiinţă a impus un moratoriu de un an asupra cercetărilor care ar putea avea ca rezultat noi variante ale virusurilor gripei aviare. Experimentele profesorului Chen s-au încheiat înainte ca această pauză să fie pusă în aplicare, dar comunitatea ştiinţifică se aşteaptă la noi cercetări de acest gen din moment ce termenul pentru moratoriu s-a încheiat.
Însă experimentul chinez nu este singular, din păcate. În martie 2012, echipa condusă de cercetătorul Ron Fouchier, din cadrul Centrului Medical Erasmus din Olanda, publica rezultatele unui studiu similar. Din cauza riscurilor evidente asupra biosecurităţii pe care le-a prezentat studiul, comunitatea oamenilor de ştiinţă a impus un moratoriu de un an asupra cercetărilor care ar putea avea ca rezultat noi variante ale virusurilor gripei aviare. Experimentele profesorului Chen s-au încheiat înainte ca această pauză să fie pusă în aplicare, dar comunitatea ştiinţifică se aşteaptă la noi cercetări de acest gen din moment ce termenul pentru moratoriu s-a încheiat.
Microbiologul Richard Ebright de la Universitatea Rutgers, care a criticat vehement studiul lui Fouchier s-a arătat sceptic şi în ceea ce priveşte cercetările efectuate de Chen. El a declarat publicaţiei Wired: „Singura diferenţă majoră între cele două experimente asupra gripei H5N1 este folosirea unor cobai de laborator diferiţi. Din punctul meu de vedere niciuna dintre cercetări nu conţine vreo informaţie nouă şi substanţială care să justifice în vreun fel riscurile majore implicate.”
Oamenii de ştiinţă nu cunosc deocamdată dacă virusurile nou create de cercetătorii chinezi sunt la fel de ucigaşe precum H5N1. Hibrizii nu au omorât niciunul dintre cobaii pe care i-au contaminat, dar Chen a afirmat că rozătoarele respective nu sunt modele adecvate pentru studiul patogenicităţii la oameni.
Referitor la aceasta, profesorul Wain Hobson a declarat: „Nu cunoaştem gradul de patogenicitate (mortalitate) în cazul oamenilor şi sperăm să nu îl aflăm niciodată. Dar dacă rata mortalităţii ar fi între 0,1 şi 20%, iar o pandemie ar afecta 500 de milioane de oameni, am putea estima orice cifră între 500 000 şi 100 de milioane de decese”.
Virusurile extrem de periculoase create în laborator pot fi folosite ca arme de ucidere în masă de elitele criminale
 Crearea unor noi virusuri patogene a fost mereu o problemă controversată în cadrul comunităţii oamenilor de ştiinţă. Unii cercetători afirmă că dacă aceste experimente se desfăşoară în medii strict supravegheate, ele conduc până la urmă la aflarea unor vaccinuri adecvate în cazul respectivelor virusuri.
Crearea unor noi virusuri patogene a fost mereu o problemă controversată în cadrul comunităţii oamenilor de ştiinţă. Unii cercetători afirmă că dacă aceste experimente se desfăşoară în medii strict supravegheate, ele conduc până la urmă la aflarea unor vaccinuri adecvate în cazul respectivelor virusuri.
Însă numeroşi cercetători din lumea întreagă sunt îngrijoraţi cu privire la răspândirea morţii care ar putea apărea dacă un astfel de virus ar depăși granițele laboratoarelor, fie în urma unei contaminări accidentale, în lipsa unui sistem de protecţie şi de securitate adecvat, fie în situația criminală a unei contaminări intenţionate.
Randall Larsen, fostul director executiv al Comisiei Congresului American asupra Prevenţiei Armelor de Distrugere în Masă şi Terorism a declarat publicaţiei The Scientist faptul că multe ţări deţin programe pentru arme biologice care intenţionează crearea unor noi virusuri letale. După ce Uniunea Sovietică s-a prăbuşit, unul dintre oamenii de ştiinţă ai perioadei comuniste a dezvăluit faptul că Uniunea Sovietică avea programe pentru crearea armelor biologice prin intermediul virusurilor Ebolla, HIV și al virusului variolic.
În plus, merită să luăm în considerare interesele sinistre ale aşa zisei „elite” mondiale a „iluminaţilor” în vederea reducerii drastice a populaţiei pământului. Unii cercetători iresponsabili percum echipa chineză care a realizat experimente îngrijorătoare cu virusul ucigaş H5N1, nu fac altceva decât să creeze şanse pentru împlinirea planurilor diabolice ale clicii de psihopaţi care ne conduc din umbră planeta.
Citiţi şi:
Nick Rockefeller recunoaşte că scopul elitei mondiale este reducerea la jumătate a populaţiei globului şi controlul prin implantul de microcipuri
Bill Gates recunoaşte că vaccinurile sunt folosite pentru reducerea populaţiei la nivel mondial
yogaesoteric
7 octombrie 2013
